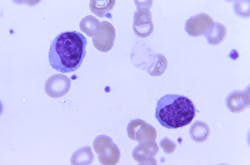
Courtesy of the CDC Courtesy of the CDC

Epstein-Barr Virus (EBV)-associated nasopharyngeal carcinoma (NPC) exhibits unusual geographic restriction despite ubiquitous lifelong infection. Screening programs can detect most NPC cases at an early stage, but existing EBV diagnostics are limited by false positives and low positive predictive value (PPV), leading to excess screening endoscopies, MRIs, and repeated testing.
Recent EBV genome-wide association studies (GWAS) suggest that EBV BALF2 variants account for more than 80% of attributable NPC risk. We therefore hypothesized that high-risk BALF2 variants could be readily detected in plasma for once-lifetime screening triage.
Researchers designed and validated a multiplex genotyping assay to detect EBV BALF2 polymorphisms in human plasma. Targeted next-generation sequencing was used to validate this assay, conduct association studies with clinical phenotype, and longitudinally genotype plasma to assess within-host haplotype stability. They examined the association between NPC and BALF2 haplotypes in a large non-endemic population and three prior EBV GWAS. Finally, they estimated NPC mortality reduction, resource utilization, and cost-effectiveness of BALF2 variant-informed screening using a previously-validated cohort model.
Following analytical validation, the BALF2 genotyping assay had 99.3% concordance with sequencing in a cohort of 24 NPC cases and 155 non-NPC controls. BALF2 haplotype was highly associated with NPC in this non-endemic population (I613V: odds ratio [OR] 7.9; V317M: OR 178.8). No other candidate BALF2 polymorphisms were significantly associated with NPC or hematologic disorders.
Longitudinal genotyping revealed 97.8% within-host haplotype concordance, indicative of lifelong latent infection. In a meta-analysis of 755 NPC cases and 981 non-NPC controls, BALF2 I613V and V317M were significantly associated with NPC in both endemic and non-endemic populations.
Modeled variant-informed screening strategies achieved a 46% relative increase in PPV with 7% decrease in effective screening sensitivity, thereby averting nearly half of screening endoscopies/MRIs among endemic populations in east/southeast Asia.
EBV BALF2 haplotypes are temporally stable within hosts and can be readily detected in plasma via an inexpensive multiplex genotyping assay that offers near-perfect sequencing concordance. In endemic and non-endemic populations, I613V and V317M were highly associated with NPC and could be leveraged to develop variant-informed screening programs that mitigate false positives with small reductions in screening sensitivity.